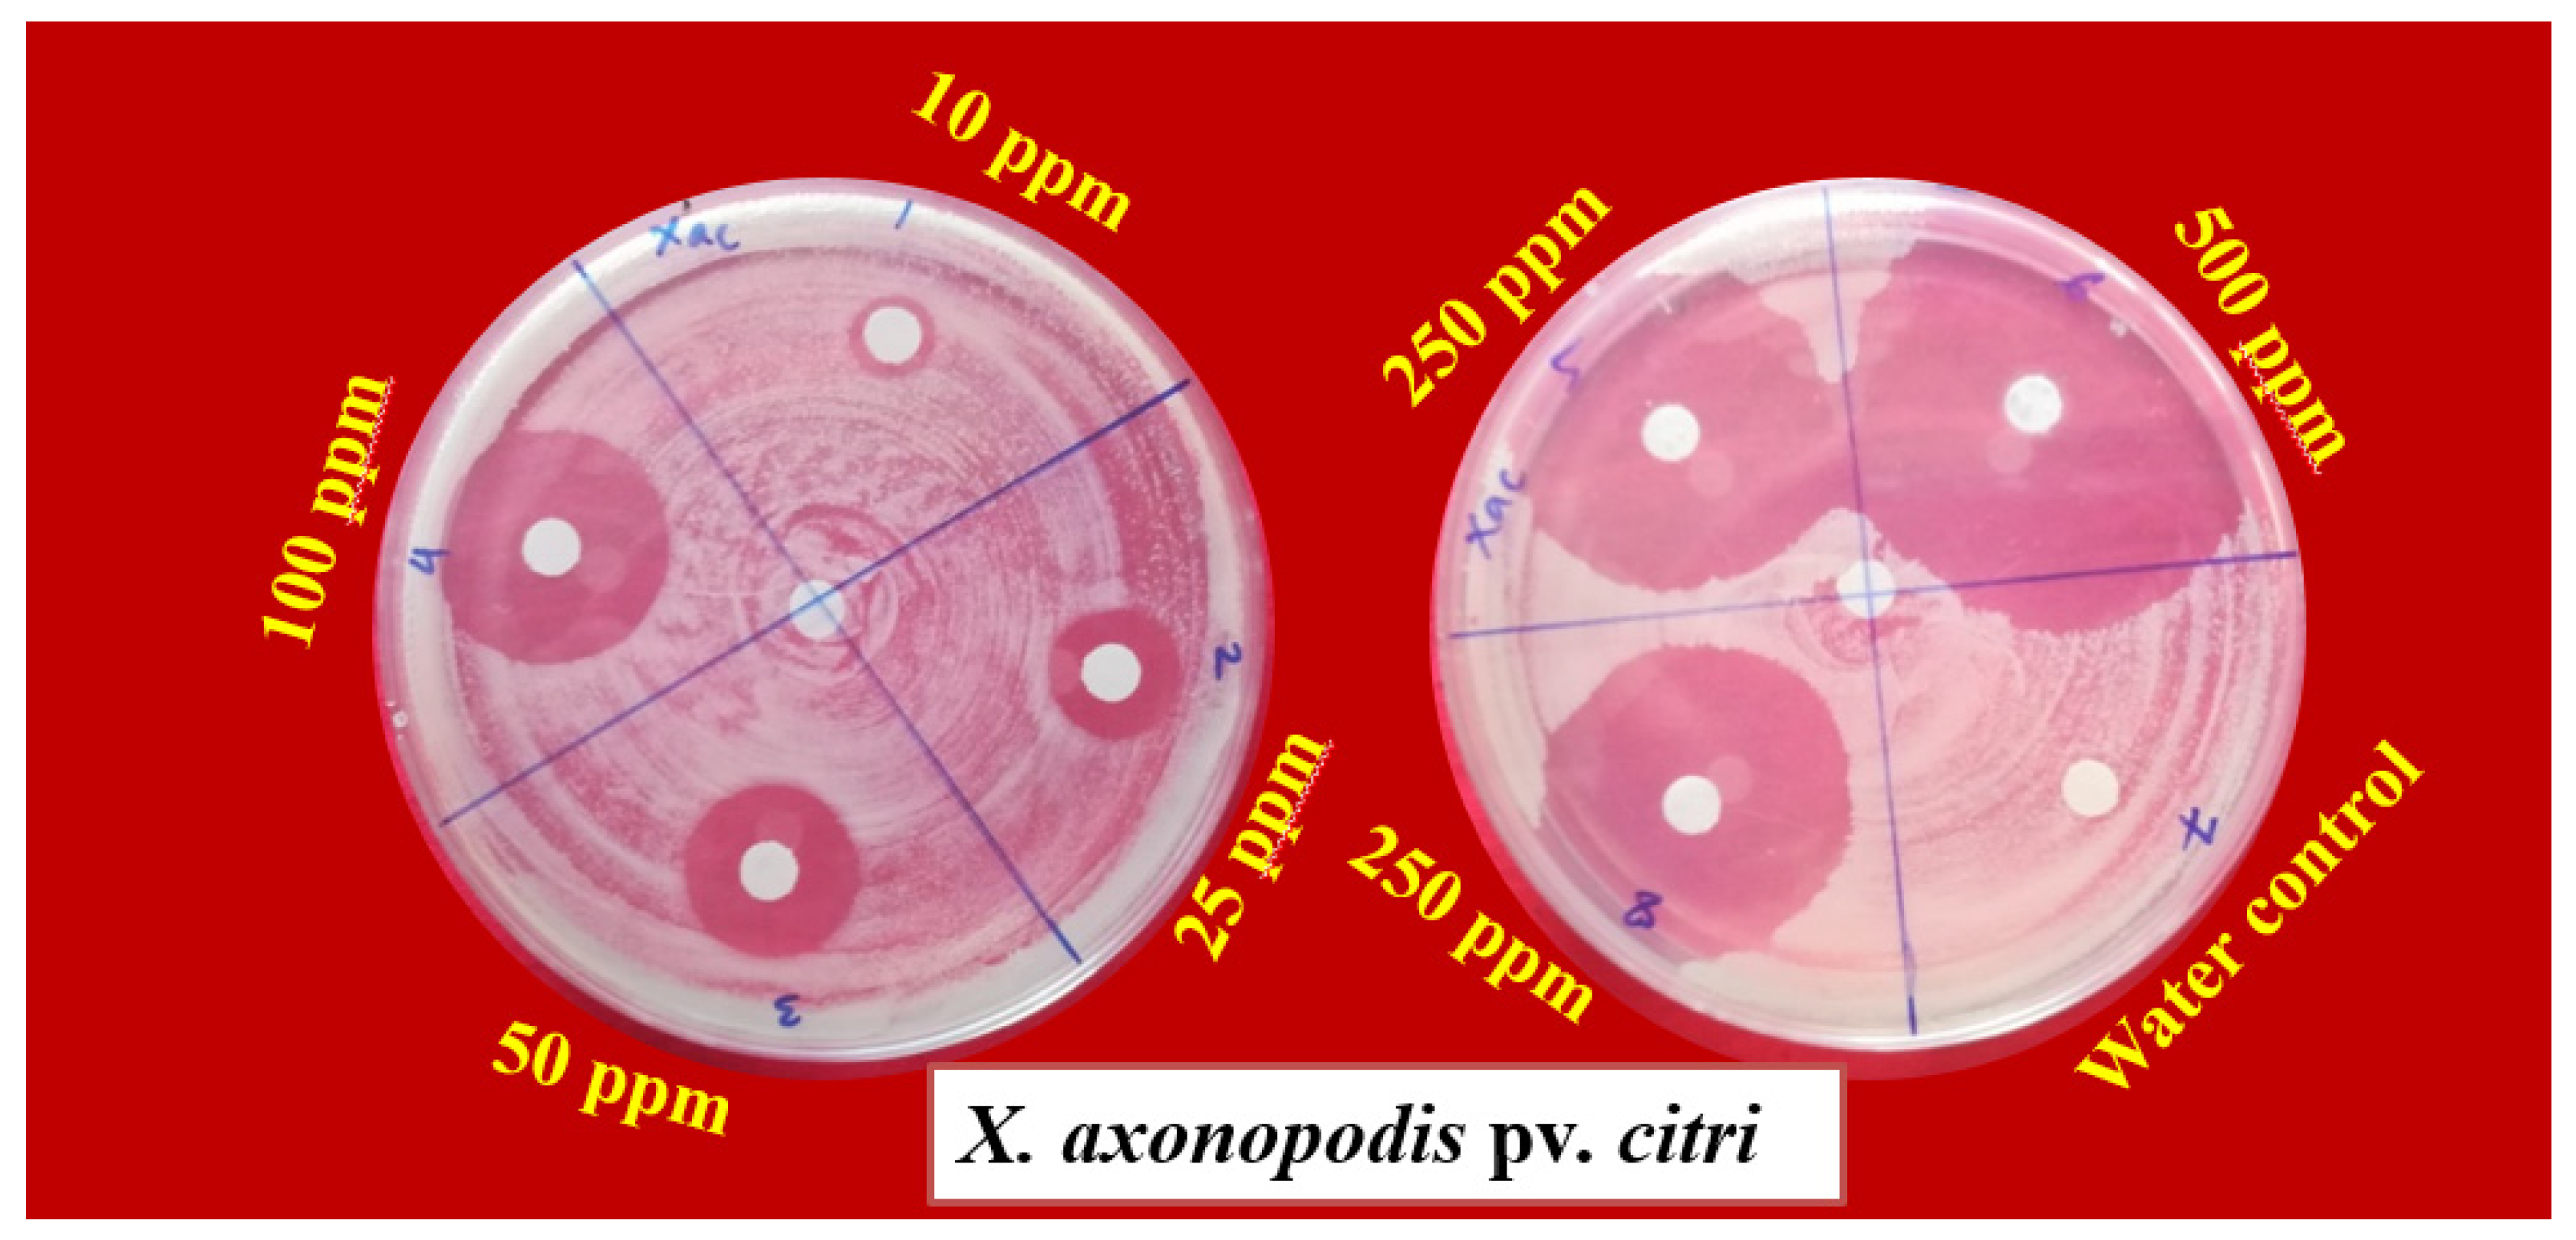
Horticulturae 07 00573 g002
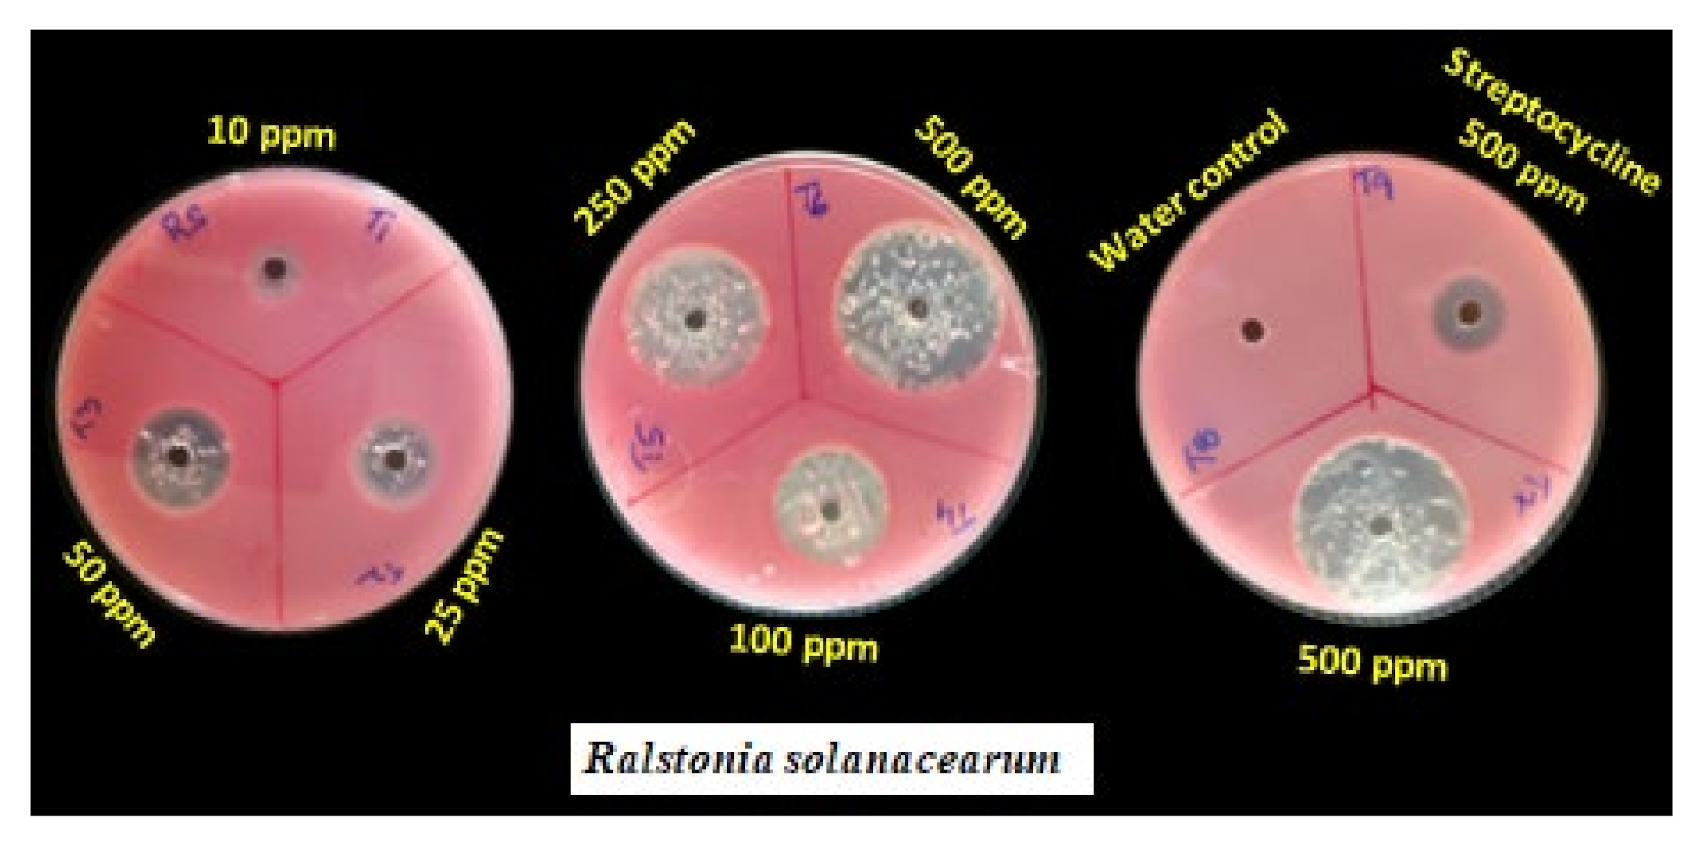
Horticulturae 07 00573 g004

Colloidal Silver Hydrogen Peroxide: New Generation Molecule for Management of Phytopathogens
Abstract
:1. Introduction
2. Material and Methods
2.1. Chemical Composition and Source
2.2. Pathogen Isolation
2.3. Morphological and Biochemical Characterisation of Test Pathogens
2.4. DNA Isolation, PCR Amplification, and Sequencing
2.5. Antibacterial Assay
2.6. Antifungal Assay
2.7. Characterisation of Silver Hydrogen Peroxide Particles
2.8. Phytotoxicity on Cotton Plants
2.9. Statistical Analysis
3. Results
3.1. Morphological and Biochemical Characterisation of Study Pathogens
3.2. Molecular Identification
3.3. Antibacterial Activity
3.4. Antifungal Activity
3.5. Analysis of Particles Size in Silver Hydrogen Peroxide
3.6. Phytotoxicity Study
4. Discussion
5. Conclusions
Author Contributions
Funding
Institutional Review Board Statement
Informed Consent Statement
Data Availability Statement
Acknowledgments
Conflicts of Interest
References
- Yadav, S.; Modi, P.; Dave, A.; Vijapura, A.; Patel, D.; Patel, M. Effect of abiotic stress on crops. In Sustainable Crop Production; Hasanuzzaman, M., Fujita, M., Filho, M.C.M.T., Nogueira, T.A.R., Galind, F.S., Eds.; Intech Open: London, UK, 2020; p. 3. [Google Scholar] [CrossRef]
- Oerke, E.C. Crop losses to pests. J. Agric. Sci. 2006, 144, 31–43. [Google Scholar] [CrossRef]
- Kumar, S. Plant disease management in India: Advances and challenges. Afr. J. Agric. Res. 2014, 9, 1207–1217. [Google Scholar]
- Panth, M.; Hassler, S.C.; Baysal-Gurel, F. Methods for management of soilborne diseases in crop production. Agriculture 2020, 10, 16. [Google Scholar] [CrossRef] [Green Version]
- Katan, J. Diseases caused by soilborne pathogens: Biology, management and challenges. J. Plant Pathol. 2017, 99, 305–315. [Google Scholar] [CrossRef]
- Raaijmakers, J.M.; Paulitz, T.C.; Steinberg, C.; Alabouvette, C.; Moënne-Loccoz, Y. The rhizosphere: A playground and battle field for soilborne pathogens and beneficial microorganisms. Plant Soil 2009, 321, 341–361. [Google Scholar] [CrossRef] [Green Version]
- Schoenen, D. Role of disinfection in suppressing the spread of pathogens with drinking water: Possibilities and limitations. Water Res. 2002, 36, 3874–3888. [Google Scholar] [CrossRef]
- Linley, E.; Denyer, S.P.; McDonnell, G.; Simons, C.; Maillard, J.Y. Use of hydrogen peroxide as a biocide: New consideration of its mechanisms of biocidal action. J. Antimicrob. Chemother. 2012, 67, 1589–1596. [Google Scholar] [CrossRef] [Green Version]
- Imlay, J.A.; Linn, S. Mutagenesis and stress responses induced in Escherichia coli by hydrogen peroxide. J. Bacteriol. 1987, 169, 2967–2976. [Google Scholar] [CrossRef] [Green Version]
- Jo, Y.K.; Kim, B.H.; Jung, G. Antifungal activity of silver ions and nanoparticles on phytopathogenic fungi. Plant Dis. 2009, 93, 1037–1043. [Google Scholar] [CrossRef] [Green Version]
- Martin, N.L.; Bass, P.; Liss, S.N. Antibacterial properties and mechanism of activity of a novel silver-stabilized hydrogen peroxide. PLoS ONE 2015, 10, e0131345. [Google Scholar] [CrossRef] [PubMed]
- Jeffers, S.N.; Martin, S.B. Comparision of two media selective for Phytophthora and Pythium species. Plant Dis. 1986, 70, 1038–1043. [Google Scholar] [CrossRef]
- Mahesha, H.S.; Ravikumar, M.R.; Suryanarayana, V.; Prabhu, S.T.; Jagadeesh, B.R. Interaction of pathogens associated with rhizome rot complex disease in ginger. Int. J. Curr. Microbiol. App. Sci. 2020, 9, 1460–1466. [Google Scholar] [CrossRef]
- Sanders, E.R. Aseptic laboratory techniques: Plating methods. JoVE 2012, 11, e3064. [Google Scholar] [CrossRef] [PubMed]
- Wenneker, M.; Verdel, M.S.W.; Groeneveld, R.M.W.; Kempenaar, C.; Van Beuningen, A.R.; Janse, J.D. Ralstonia (Pseudomonas) solanacearum race 3 (biovar 2) in surface water and natural weed hosts: First report on stinging nettle (Urtica dioica). Eur. J. Plant Pathol. 1999, 105, 307–315. [Google Scholar] [CrossRef]
- Kelman, A. The relationship of pathogenicity of Pseudomonas solanacearum to colony appearance in a tetrazolium medium. Phytopathology 1954, 44, 693–695. [Google Scholar]
- Bradbury, J.F. Guide to Plant Pathogenic Bacteria; CAB International: Slough, UK, 1986. [Google Scholar]
- Schaad, N.W. Laboratory Guide for Identification of Plant Pathogenic Bacteria; APS Press: St. Paul, MN, USA, 1988; pp. 1–15. [Google Scholar]
- White, T.J.; Bruns, T.; Lee, S.; Taylor, J. Amplification and direct sequencing of fungal ribosomal RNA genes for phylogenetics. PCR Protoc. A Guide Methods Appl. 1990, 18, 315–322. [Google Scholar]
- Heuer, H.; Krsek, M.; Baker, P.; Smalla, K.; Wellington, E.M. Analysis of actinomycete communities by specific amplification of genes encoding 16S rRNA and gel-electrophoretic separation in denaturing gradients. Appl. Environ. Microbiol. 1997, 63, 3233–3241. [Google Scholar] [CrossRef] [PubMed] [Green Version]
- Heatley, N.G. A method for the assay of penicillin. Biochem. J. 1944, 38, 61–65. [Google Scholar] [CrossRef] [PubMed] [Green Version]
- Vincent, J.M. Distortion of fungal hyphae in the presence of certain inhibitors. Nature 1927, 150, 850. [Google Scholar] [CrossRef]
- Nalini, S.; Parthasarathi, R. Optimization of rhamnolipid biosurfactant production from Serratia rubidaea SNAU02 under solid-state fermentation and its biocontrol efficacy against Fusarium wilt of eggplant. Ann. Agrar. Sci. 2018, 16, 108–115. [Google Scholar] [CrossRef]
- Hahn, M. The rising threat of fungicide resistance in plant pathogenic fungi: Botrytis as a case study. J. Chem. Biol. 2014, 7, 133–141. [Google Scholar] [CrossRef] [PubMed] [Green Version]
- Hollomon, D.W. Fungicide resistance: Facing the challenge—A review. Plant Prot. Sci. 2015, 51, 170–176. [Google Scholar] [CrossRef]
- Chen, C.; Qian, Y.; Chen, Q.; Tao, C.; Li, C.; Li, Y. Evaluation of pesticide residues in fruits and vegetables from Xiamen, China. Food Control 2011, 22, 1114–1120. [Google Scholar] [CrossRef]
- Grewal, A.S. Pesticide residues in food grains, vegetables and fruits: A hazard to human health. J. Med. Chem. Toxicol. 2017, 2, 1–7. [Google Scholar] [CrossRef]
- Mihajlovic, M.; Rekanovic, E.; Hrustic, J.; Grahovac, M.; Tanovic, B. Methods for management of soilborne plant pathogens. J. Pestici. Phytomedic. 2017, 32, 9–24. [Google Scholar] [CrossRef]
- Yurudu, N.O.S.; Erdem, A.K. Evaluation of the antimicrobial activity of colloidal silver-hydrogen peroxide against model cooling tower biofilm. In The Battle against Microbial Pathogens; Méndez-Vilas, A., Ed.; Formatex Research Centre: Badajoz, Spain, 2015; pp. 526–533. [Google Scholar]
- Lin, S.; Taylor, N.J.; Peduto Hand, F. Identification and characterization of fungal pathogens causing fruit rot of deciduous holly. Plant Dis. 2018, 102, 2430–2445. [Google Scholar] [CrossRef] [PubMed]
- Armitage, A.D.; Barbara, D.J.; Harrison, R.J.; Lane, C.R.; Sreenivasaprasad, S.; Woodhall, J.W.; Clarkson, J.P. Discrete lineages within Alternaria alternata species group: Identification using new highly variable loci and support from morphological characters. Fungal Biol. 2015, 119, 994–1006. [Google Scholar] [CrossRef]
- Debnath, A.; Bandyopadhyay, S.; Dutta, S. Symptomatological variation of rhizome rot-wilt complex disease of ginger under Terai agro-ecological region of West Bengal. Environ. Ecol. 2009, 27, 1–4. [Google Scholar]
- Rodrigues, L.M.R.; Destefano, S.A.L.; Da Silva, M.J.; Costa, G.G.L.; Maringoni, A.C. Characterization of Ralstonia solanacearum strains from Brazil using molecular methods and pathogenicity tests. J. Plant Pathol. 2012, 94, 505–516. [Google Scholar]
- Islam, M.N.; Ali, M.S.; Choi, S.J.; Hyun, J.W.; Baek, K.H. Biocontrol of citrus canker disease caused by Xanthomonas citri sub sp. citri using an endophytic Bacillus thuringiensis. Plant Pathol. J. 2019, 35, 486. [Google Scholar] [CrossRef] [PubMed]
- Doddaraju, P.; Kumar, P.; Gunnaiah, R.; Gowda, A.A.; Lokesh, V.; Pujer, P.; Manjunatha, G. Reliable and early diagnosis of bacterial blight in pomegranate caused by Xanthomonas axonopodis pv. punicae using sensitive PCR techniques. Sci. Rep. 2019, 9, 10097. [Google Scholar] [CrossRef] [PubMed] [Green Version]
- Davoudi, M.; Ehrampoush, M.H.; Vakili, T.; Absalan, A.; Ebrahimi, A. Antibacterial effects of hydrogen peroxide and silver composition on selected pathogenic enterobacteriaceae. Int. J. Environ. Health Eng. 2012, 1, 23. [Google Scholar]
- Sattar, S.A.; Springthorpe, V.S.; Rochon, M. A product based on accelerated and stabilized hydrogen peroxide: Evidence for broad-spectrum germicidal activity. Can. J. Infect. Control 1998, 13, 123–130. [Google Scholar]
- Moawad, A.; El-Midany, S. A new generation of hydrogen peroxide as a fungicidal disinfectant in rabbit houses. Kafrelsheikh Vet. Med. J. 2009, 7, 96–114. [Google Scholar] [CrossRef]
- Kumar, S.; Singh, M.; Halder, D.; Mitra, A. Mechanistic study of antibacterial activity of biologically synthesized silver nanocolloids. Colloids Surf. A 2014, 449, 82–86. [Google Scholar] [CrossRef]
- Suganya, K.S.U.; Govindaraju, K.; Kumar, V.G.; Dhas, T.S.; Karthick, V.; Singaravelu, G.; Elanchezhiyan, M. Size controlled biogenic silver nanoparticles as antibacterial agent against isolates from HIV infected patients. Spectrochim. Acta Part A Mol. Biomol. Spectrosc. 2015, 144, 266–272. [Google Scholar] [CrossRef]
- Dakal, T.C.; Kumar, A.; Majumdar, R.S.; Yadav, V. Mechanistic basis of antimicrobial actions of silver nanoparticles. Front. Microbiol. 2016, 7, 1831. [Google Scholar] [CrossRef] [PubMed] [Green Version]

| Sl. No. | Pathogen | Host | Plant Part Used for Isolation | Latitude and Longitudes |
|---|---|---|---|---|
| 1 | Pythium aphanidermatum | Ginger- Zingiber officinale | Pseudostem | N14.5296 E75.0210 |
| 2 | Fusarium solani | Ginger- Z. officinale | Rhizomes | N14.5296 E75.0210 |
| 3 | Ralstonia solanacearum | Tomato- Solanum lycopersicum | Stem | N15.2930 E74.5909 |
| 4 | Xanthomonas citri pv. punicae | Pomegranate- Punica granatum | Fruits | N16.7641 E75.7478 |
| 5 | X. axonopodis pv. citri | Lemon- Citrus sp. | Fruits | N15.2930 E74.5909 |
| Biochemical Test | X. axonopodis pv. Citri | X. citri pv. Punicae | R. solanacearum |
|---|---|---|---|
| Gram staining | − | − | − |
| KOH test | + | + | + |
| Starch hydrolysis | + | + | + |
| Hydrogen sulphide production | + | + | + |
| Catalase test | + | + | + |
| Treatments | Concentrations (ppm) | Mycelial Inhibition (%) | |
|---|---|---|---|
| F. solani | P. aphanidermatum | ||
| Silver hydrogen peroxide | 1000 | 0.00 c (0.00) * | 0.00 c (0.00) |
| Silver hydrogen peroxide | 5000 | 100.00 a (90.00) | 100.00 a (90.00) |
| Silver hydrogen peroxide | 10,000 | 100.00 a (90.00) | 100.00 a (90.00) |
| Silver hydrogen peroxide | 20,000 | 100.00 a (90.00) | 100.00 a (90.00) |
| Silver hydrogen peroxide | 30,000 | 100.00 a (90.00) | 100.00 a (90.00) |
| Silver hydrogen peroxide | 40,000 | 100.00 a (90.00) | 100.00 a (90.00) |
| Silver nitrate | 3 mM | 3.70 b (11.09) | 3.70 b (11.09) |
| Carbendazim 50% WP | 1000 | 100.00 a (90.00) | - |
| Metalaxyl 4%+ Mancozeb 64% WG | 1500 | - | 100.00 a (90.00) |
| S. Em. ± | 0.29 | 0.48 | |
| CD @ 1% | 0.88 | 1.40 | |
| SHP Concentration (ppm) | Phytotoxicity Rating |
|---|---|
| 10 | 0 * |
| 25 | 0 |
| 50 | 0 |
| 100 | 0 |
| 250 | 0 |
| 500 | 0 |
| 1000 | 0 |
| 5000 | 0 |
| 10,000 | 5 |
Publisher’s Note: MDPI stays neutral with regard to jurisdictional claims in published maps and institutional affiliations. |
© 2021 by the authors. Licensee MDPI, Basel, Switzerland. This article is an open access article distributed under the terms and conditions of the Creative Commons Attribution (CC BY) license (https://creativecommons.org/licenses/by/4.0/).
Share and Cite
Mahesha, H.S.; Vinay, J.U.; Ravikumar, M.R.; Visweswarashastry, S.; Keerthi, M.C.; Halli, H.M.; Shokralla, S.; El-Abedin, T.K.Z.; Mahmoud, E.A.; Elansary, H.O. Colloidal Silver Hydrogen Peroxide: New Generation Molecule for Management of Phytopathogens. Horticulturae 2021, 7, 573. https://doi.org/10.3390/horticulturae7120573
Mahesha HS, Vinay JU, Ravikumar MR, Visweswarashastry S, Keerthi MC, Halli HM, Shokralla S, El-Abedin TKZ, Mahmoud EA, Elansary HO. Colloidal Silver Hydrogen Peroxide: New Generation Molecule for Management of Phytopathogens. Horticulturae. 2021; 7(12):573. https://doi.org/10.3390/horticulturae7120573
Chicago/Turabian StyleMahesha, Hosapura Shekhararaju, Jayasuvarnapura Umapathi Vinay, Medikeripura Rekhyanaik Ravikumar, Suryanarayana Visweswarashastry, Manikyanahalli Chandrashekhara Keerthi, Hanamant Mudakappa Halli, Shadi Shokralla, Tarek K. Zin El-Abedin, Eman A. Mahmoud, and Hosam O. Elansary. 2021. "Colloidal Silver Hydrogen Peroxide: New Generation Molecule for Management of Phytopathogens" Horticulturae 7, no. 12: 573. https://doi.org/10.3390/horticulturae7120573
APA StyleMahesha, H. S., Vinay, J. U., Ravikumar, M. R., Visweswarashastry, S., Keerthi, M. C., Halli, H. M., Shokralla, S., El-Abedin, T. K. Z., Mahmoud, E. A., & Elansary, H. O. (2021). Colloidal Silver Hydrogen Peroxide: New Generation Molecule for Management of Phytopathogens. Horticulturae, 7(12), 573. https://doi.org/10.3390/horticulturae7120573

